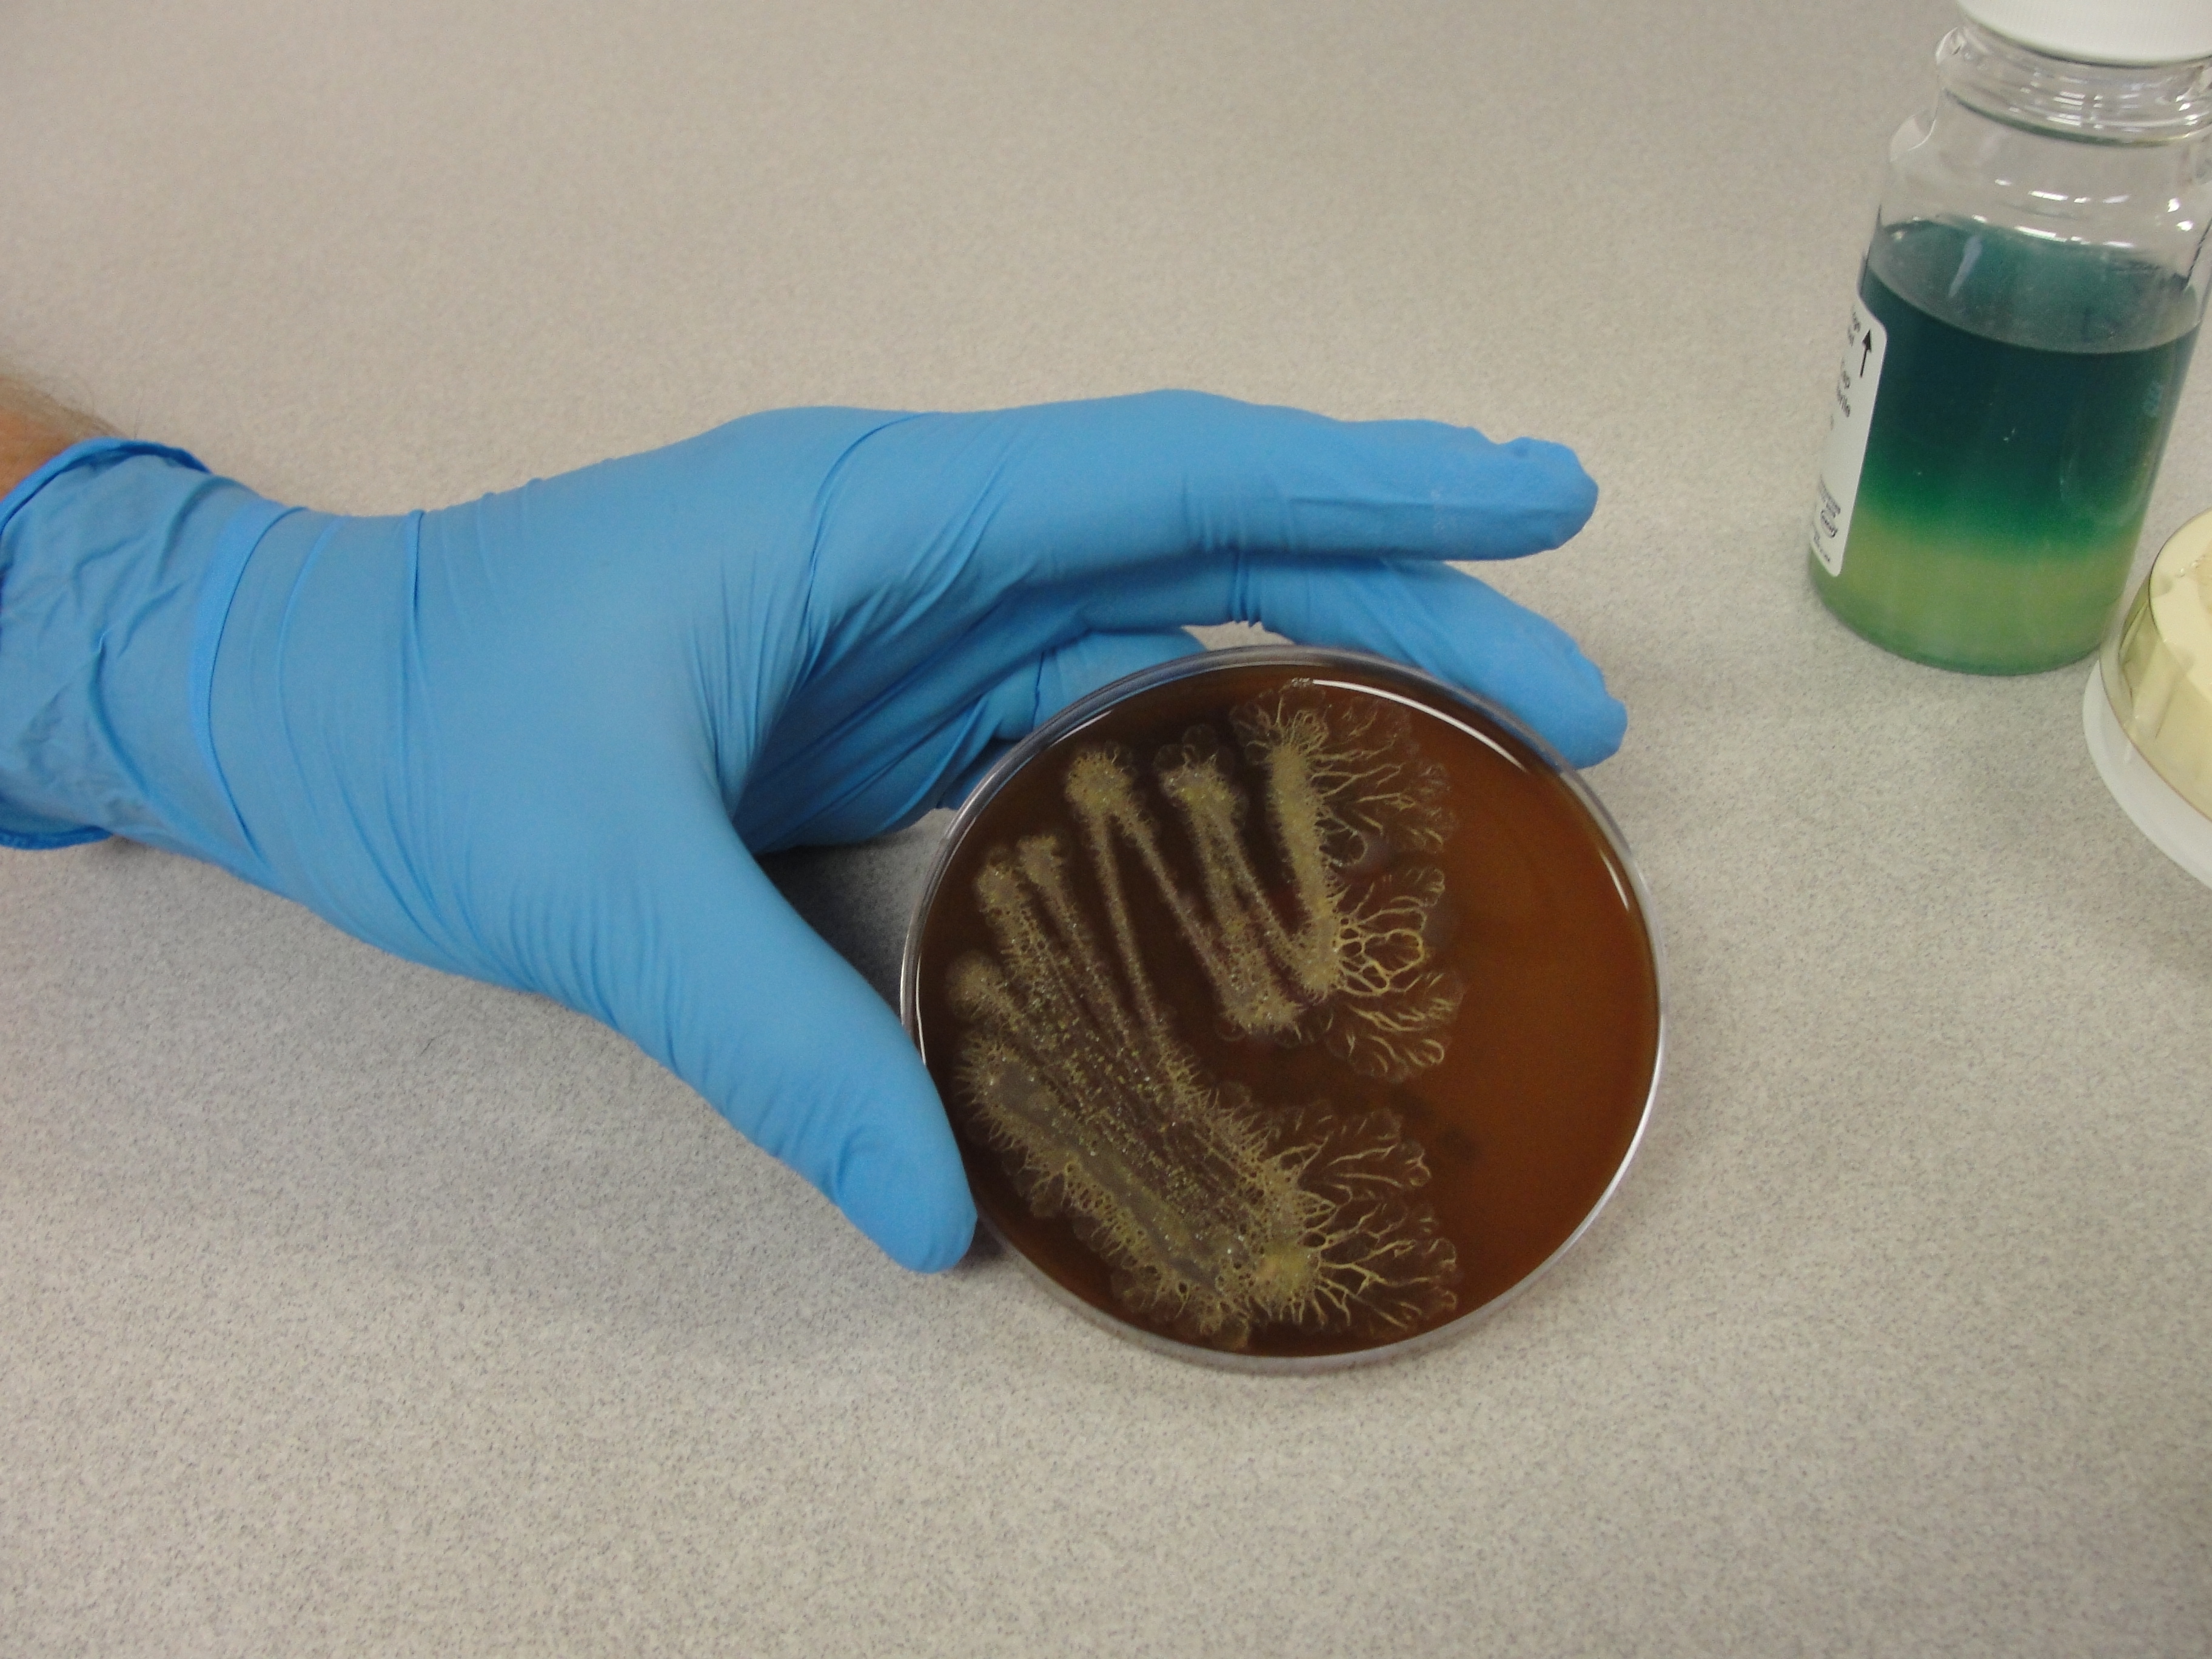

Water well disinfection is one of the most common forms of maintenance performed; it is also one of the most misunderstood procedures in our industry. Water well disinfection is typically employed for one of two reasons, mandated or reactionary.
As a mandated procedure, it is conducted following development of new wells prior to placing the well into active use, or, in the case of existing wells, if any maintenance has been conducted, including pump work, rehabilitation, or modification. As a reactionary procedure, disinfection is conducted in response to a coliform "hit" or as a rehabilitation effort in response to a loss of capacity or produced water quality.
The first issue to address is the limitations of well disinfection. Disinfection will not solve a significant loss of capacity, it will not target heavy mineral scale, it will not sterilize the well, nor will it solve a breach of the well structure.
Disinfection is used as a means of reducing the bacterial community and limiting the potential for pathogenic organisms to exist within the well, not clean the well. Disinfection failures often stem from one of several reasons, including improper use or application of the chemicals, insufficient agitation or contact time, and commonly, suspected fouling being greater than anticipated.
The second issue to examine is the use and employment of the disinfection solution. Chlorine has been used to treat water since the late 1800's, and remains today as the most common chemical used to treat well systems.
Chlorine is available in the gas, liquid, and solid forms. As a gas, chlorine is very dangerous, and its use as a disinfectant should be limited to a controlled environment such as a water treatment plant.
Forms of chlorine
In the liquid form, commonly as sodium hypochlorite, chlorine is available in a variety of strengths. At the grocery or local discount store, you can purchase a 3 to 6 percent solution as "bleach" - however, be sure not to get a scented or "enhanced" formula as it may include perfumes or other compounds not safe for downhole use.
From a chemical supplier, you should be able to get a stronger solution ranging from 10 to 15 percent strength. Sodium hypochlorite degrades overtime, with exposure to sunlight, and with changes in temperature. It is estimated that with every month, liquid sodium hypochlorite degrades in strength by 1 percent.
With this in mind, it is advised that you always secure a fresh, sealed container of sodium hypochlorite for each well disinfection project. Calcium hypochlorite is the common granular or tablet form of chlorine. As a mixture, it contains calcium carbonate, and calcium chloride.
It is marketed as chlorine powder or bleach powder for water treatment and as a bleaching agent. Calcium hypochlorite is as a 25 percent, 33 percent, 68 percent, and 73 percent active product, which means it contains that amount of available chlorine by weight.
As with most powdered chemicals, it should be dissolved in water prior to introduction into the well. Calcium hypochlorite is commonly used in a variety of water systems, including wells, pools, cooling towers, and storage tanks.
Due to the amounts of calcium present, it is important not to use calcium hypochlorite in ground water environments that exhibit high hardness as it can introduce calcium into an already saturated environment, causing scale formation.


Most commercial forms of chlorine, including liquid and solid hypochlorite solutions, are buffered for safety. This is done to limit the potential for chlorine gas formation which is very dangerous, as well as to reduce the potential for corrosion or damage from the oxidizing effects of chlorine.
Buffering to a higher, more alkaline pH, limits the biocidal effectiveness of hypochlorite solutions, resulting in a need for greater concentrations of the chlorine product.
Concentrations of chlorine
When sodium or calcium hypochlorite is mixed with water, both hypochlorous and hypochlorite ions are formed. The hypochlorous ion is considered to be several hundred times more biocidal than the chlorine residual formed by the hypochlorite ion, and as such is the greater means of disinfection during treatment.
The hypochlorous ion is present in greater concentration (strength) at lower pH values. For example, at a pH of 6.5, the hypochlorous ion content is near 95 percent strength; at a pH of 7.5, the hypochlorous and hypochlorite ions will be present in near equal concentrations, with only minimal biocidal effectiveness; and as the pH passes 8.0, the hypochlorous ion content falls to less than 4 percent, hindering biocidal activity significantly.
The hypochlorite ion predominates above pH 8.3. This phenomenon is why many disinfection efforts fail. As such, you will need to identify the pH of your source water (for mixing), as well as the alkalinity, to identify the neutralizing potential of the water prior to chlorine addition.
Adjusting the pH of the treatment solution to a range of 6.5 to 7.0 will improve the biocidal efforts by allowing for the maximum production of hypochlorous acid, the biocidal form of chlorine. Research has shown that concentrations of chlorine above 500 ppm generally fail in effective removal of the offending organisms (coliforms).
The age old theory of "shock chlorination" came about due to the limitations of pH and the need to apply more and more chlorine to achieve only minor biocidal activity. In new wells, with less biofilm and free iron present, chlorine concentrations of 50 to 150 ppm are typically needed.
In older wells that have exhibited higher fouling, generally concentrations of 200 to 300 ppm are utilized. In addition to buffering the pH and selection of the chlorine compound, how you apply it a very important choice. Dumping a solution from the top often fails to reach the target area.
While it is true that chlorine has a higher specific gravity than water, it is generally not sufficient to overcome the volumetric difference within the well column or remain effective as it dilutes in the well.
Hypochlorite solutions
Several years ago our laboratory conducted a series of experiments designed to determine the distribution and dispersal patterns of hypochlorite solutions when added to the well. We found that a hypochlorite solution designed to deliver 300ppm chlorine to a well if added to the top of the water level took as much as 6 hours to achieve saturation at the well bottom and an additional six hours to distribute throughout the gravel pack.


This indicated that if the chlorine dose is added to the top of the water column and removed within the first six hours, less than half of the well surfaces are exposed to a biocidal concentration of chlorine. Thus, for effective disinfection, you need to insure that you are delivering the prepared solution throughout the water column. Using a tremie pipe or similar means of application, you should spot the treatment solution evenly throughout the well, starting at the bottom and working upwards.
Disinfection process
Let's walk through the disinfection process. When chlorinating a new or existing well, several factors can improve the effectiveness. First, as with any procedure, you need to identify your goals and the well's condition.
Evaluate the well from the surface to rule out potential contamination, vandalism, or any means of potential surface or near surface influence on the well. For both new and old wells, it is advised to actively flush the well prior to treatment.
For older wells, performing pre-treatment cleaning or evacuation of the well prior to chlorination reduces the amount of biomass and debris that can readily degrade chlorine. Second, determine the pH and alkalinity of your mix water, as well as identify your desired chlorine concentration. By confirming the pH and alkalinity, you can identify the need for use of a chlorine enhancer and identity the correct dosage.
This will allows you maximum production of hypochlorous acid, the biocidal form of chlorine, during treatment. Third, target a treatment volume sufficient to flood the entire well, borehole, and near-well aquifer with the chlorination solution. We recommend using a value equivalent to three to four times the standing well volume. Fourth, do not shock the well! Target a chlorine concentration between 50 and 400 ppm for effective results.
Utilizing fresh sodium hypochlorite, in a 10 to 12 percent strength solution, is recommended over powdered calcium hypochlorite as it does not add any additional calcium to the well setting. Fifth, adding the chlorine into the well via a tremie pipe and making an effort to evenly distribute the solution throughout the entire well column will direct the solution to the areas it is needed. Applying agitation once the solution is in place will help disperse the solution throughout the targeted treatment area. Allow for sufficient contact time so that the chlorine can go to work.
As a rule of thumb, multiply the chlorine concentration by the contact time, in hours, to a minimum of 1000 "contact units". Thus, if you are using a solution of 250 ppm, you'll need a minimum of 4 hours contact time. When possible, allow the solution to stand overnight, downhole with periodic agitation. During chlorination efforts, we advise regular monitoring of the downhole solution to insure sufficient chlorine remains. There are several commercially available test strips that allow you to monitor the chlorine residual.
It is recommended that you strive to maintain a minimum active concentration of 50ppm downhole during treatment. Once chlorination is complete, begin evacuation of the well from the bottom, working upwards, until all debris has been evacuated from the well. Monitor your chlorine concentration to insure evacuation of the treatment solution. It is also advised that you monitor conductivity and visual turbidity to insure that all disrupted material has been evacuated from the well. Once disinfection efforts are completed, the well should be returned to an active operating schedule as soon as possible.
Disposal of the chlorine solution is a growing concern, with regulations present in many States. The basic procedure is to capture the evacuated fluids and neutralize the chlorine content prior to disposal. There are a variety of chlorine neutralizing products on the market including NW-500, sodium bisulfite, sodium thiosulfate, and ascorbic acid. Prior to evacuation, estimate the volume of water you will discharge from the well to adequately flush the chlorine solution. Provide for a tank sufficient to hold the evacuated solution or a portion of it.
Measure the chlorine level of the water and calculate the dose of the selected neutralizer required. Monitor the chlorine level within the tank to insure adequate neutralization. Once sufficiently de-chlorinated, the solution can generally be safely discharged. Check your local laws and regulation to insure you are operating correctly. Well disinfection is a common but important form of maintenance.
The hazards, costs, and potential impacts of chlorination dictate that the procedure should be part of a scientific based process - take the time to evaluate the well, securing laboratory samples, pump data, or even a well video to correctly identify the condition of the well, need for disinfection, and the methods employed, prior to beginning treatment. Misapplication of chlorine, a strong oxidizing chemistry, can damage new wells, cause failure of existing fouled wells, and present a potential hazardous condition for the crew and environment - take the time to understand the problem downhole and do it right!